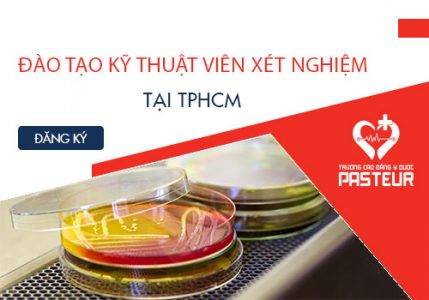

Nhằm giúp cho các thí sinh có quyết định đúng đắn cho tương lai của mình, ban tư vấn tuyển sinh sẽ giải đáp việc “Học cao đẳng xét nghiệm ra trường có nhiều cơ hội việc làm không?” qua nội dung bài viết sau.
Danh mục: Cao đẳng Xét nghiệm TPHCM
Miễn 100% học phí khi theo học hệ Cao đẳng Y Dược TpHCM năm 2018
Thông báo miễn 100% học phí cho các thí sinh đăng ký học các ngành thuộc hệ cao đẳng y dược TpHCM tại trường cao đẳng y dược Pasteur năm 2018. Thời gian đào tạo Cao đẳng Dược Tp.HCM hệ chính quy năm 2018 Trường Cao đẳng Y Dược Pasteur có xét tuyển khối ngành khoa học xã hội không? Chỉ tiêu tuyển sinh Cao đẳng điều dưỡng Tp.HCM năm…